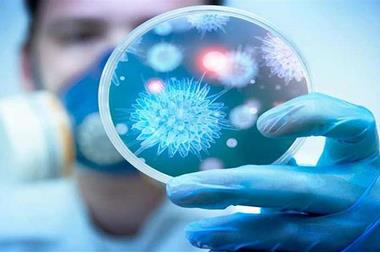

العاب تقى

لعبة تلبيس واظهار الحب لعبة جديدة وقويه من ألعاب تقي العبيها الان قومي بتلبيس الفتاة التي تظهر امامك علي اللعبة الملابس ولا تدعي فرصة لغيرك كي تكون موجوده معك العبيها الان علي العاب تقي في البداية تضغطين علي start.
العاب تقى. ألعاب بنات تلبيس اللاعبات محبات الأزياء قومي بتلبيس البنات المفضلات لك في واحدة من ألعابنا المجانية العديدة عبر الإنترنت اختر إحدى ألعابنا المجانية استمتع وامرح. العاب تلبيس بنات العاب تقي موقع العاب بنات يحتوي علي أفضل الالعاب للعام 2020 العاب تلبيس رائعة اكثر لعبة تلبيس بنات جديده داخل موقع العاب تلبيس سولي يمكنكي سدتي ايجاد العديد والعديد من الالعاب الشيقه جدا والممتعه في نفس. العاب تلبيس أسرة تقي السعيدة انتي الان داخل موقع العاب تقي لذلك مهمتك الان هلي تلبيس اسرة تقي جميه الملابس وكما تعلمين ان اسرة تقي تتكون من أب و أم أخ صغير ل تقي قومي بتلبيسهم جميعا حيث المناسبه القوية التي يرديون. ألعاب فلاش أفضل الألعاب المسلية ألعاب أطفال ألعاب بنات العاب تقي موقع العاب فلاش عربي يحتوي على العاب البنات والسيارات والاكشن والاطفال والكرتون والمكياج والتلبيس والطبخ والكثير من.
العاب باربي هو موقع متخصص في العاب باربي فقط مثل العاب تلبيس باربي و العاب طبخ باربي و العاب. لعبة تلبيس تقي البيجامات قومي بتلبيس تقي البيجامات داخل غرفة النوم مجموعة رائعة من البيجامات التي تقومين بتلبيسها لتقي حتي تستطيع الذهاب الي النوم بكل سهولة وكما هو معروف داخل العاب تلبيس بنات تقي أنه.